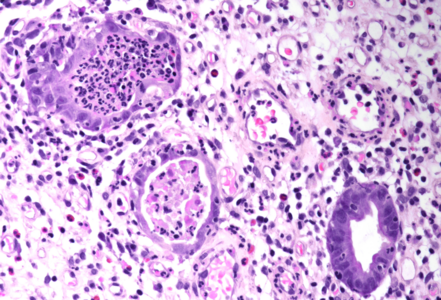
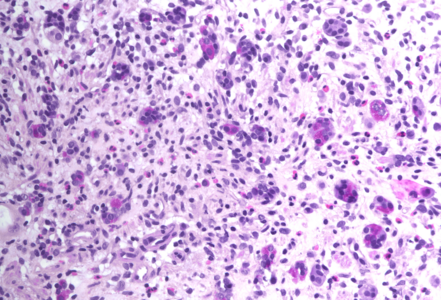

-
Die Universität
- Herzlich willkommen
- Das sind wir
- Medien & PR
-
Studium
- Allgemein
- Studienangebot
- Campusleben
-
Forschung
- Profil
- Infrastruktur
- Kooperationen
- Services
-
Karriere
- Arbeitgeberin Med Uni Graz
- Potenziale
- Arbeitsumfeld
- Offene Stellen
-
Diagnostik
- Patient*innen
- Zuweiser*innen
- Gesundheitsthemen
- Gesundheitsinfrastruktur
Case of the Month
July 2023
Gastric biopsies from a 68-year-old male with history of lung cancer.
Diagnosis
Immune checkpoint inhibitor associated gastritis.
Comment
Nearly four years previously, the patient was diagnosed with lung cancer. The histopathological evaluation revealed two tumours: an adenocarcinoma and a squamous cell carcinoma – without lymph node metastasis. Two years later, the adenocarcinoma recurred (local recurrence, lymph node spread) and, since then, he was on pembrolizumab immunotherapy. The endoscopic procedure was prompted by complaints of upper abdominal pain and biopsies were taken.
Histology showed an extremely altered gastric mucosa, with architectural distortion by glandular atrophy, degenerative epithelial changes, erosions and an expanded oedematous lamina propria (PANEL A-C). On higher magnification, the lamina propria contained a mixed inflammatory infiltrate, characterized by lymphocytes, plasma cells, eosinophils and neutrophils, focally with abscess formation. We observed withering glands lined by flattened eosinophilic epithelium, occasionally containing apoptotic debris (PANEL D-E); in other areas, little atrophic neuroendocrine nests were found (PANEL F). In summary, there was a severe acute inflammation and signs of acute epithelial injury highly suggestive of a drug-induced gastritis, consistent with injury due to pembrolizumab.
This drug belongs to the group of immune checkpoint inhibitors (ICI) which are widely used in oncology. Specifically, this humanized antibody targets the programmed cell death protein 1 (PD-1) receptor of lymphocytes, thereby preventing it from binding to ligands that deactivate the anti-tumour immune response. ICIs are known to induce different types of immune-mediated injury, namely in skin, bowel, endocrine glands, lungs, and liver. Gastrointestinal adverse events are commonly reported, being the lower gastrointestinal toxicity more frequent than the upper counterpart. Upper gastrointestinal symptoms may be secondary to toxic immune damage of the stomach, duodenum, or small bowel; involvement of these organs may occur within 1 or 2 months after starting the therapy or later during the treatment.
Endoscopically, the most common abnormality reported in stomach was erythema followed by erosions; other findings like granularity, sloughing, exudates, ulcer, atrophy, and rarely, severe hemorrhagic gastritis, have also been reported.
The histopathologic patterns of gastric injury include (i) chronic active gastritis, (ii) lymphocytic gastritis, and (iii) focal enhanced gastritis and periglandular inflammation. The chronic active gastritis pattern, commonly coming along with increased apoptosis and severe reactive changes of the epithelium, is the most common form of ICI-associated injury. The morphology resembles chronic active gastritis in Helicobacter pylori infection; it is characterized by increased lamina propria lymphoplasmacytic infiltrate and increased intraepithelial neutrophils with or without gland abscess, affecting equally the gastric body and antrum. In contrast from concurrent intraepithelial lymphocytosis in chronic active gastritis, lymphocytic gastritis pattern without accompanying active gastritis has been reported. On the other hand, the focal enhanced gastritis pattern in ICI-induced gastric injury is characterized by small collections of lymphocytes and histiocytes around a small group of actively inflamed gastric foveolar/glandular epithelium mimicking gastric involvement by Crohn’s disease. Of note, ICI-induced gastric injury can be seen in up to 40% of gastric biopsies from patients who received ICI therapy.
Regarding the pattern of injury, the differential diagnosis includes infectious causes for gastritis (e.g. Helicobacter pylori), lymphocytic gastritis, inflammatory bowel disease (especially Crohn’s disease) with gastric involvement, and other forms of gastritis due to secondary causes.
Treatment of gastrointestinal symptoms depends on severity of (endoscopic and histological) presentation and consists of discontinuing immunotherapy until symptom resolution and/or initiating corticosteroid therapy.
For further reading
- Patil PA, Zhang X. Pathologic Manifestations of Gastrointestinal and Hepatobiliary Injury in Immune Checkpoint Inhibitor Therapy. Arch Pathol Lab Med. 2021;145:571-582.
- Zhang M L, Neyaz A, Patil D. Immune-related adverse events in the gastrointestinal tract: diagnostic utility of upper gastrointestinal biopsies. Histopathology. 2020;76:233–243.
- Collins M, Michot JM, Danlos FX, et al. Inflammatory gastrointestinal diseases associated with PD-1 blockade antibodies. Ann Oncol. 2017 1;28:2860-2865.
- Zhang ML, Deshpande V. Histopathology of Gastrointestinal Immune-related Adverse Events: A Practical Review for the Practicing Pathologist. Am J Surg Pathol. 2022;46:e15-e26.
- Dougan M, Wang Y, Rubio-Tapia A, Lim JK. AGA Clinical Practice Update on Diagnosis and Management of Immune Checkpoint Inhibitor Colitis and Hepatitis: Expert Review. Gastroenterology. 2021;160:1384-1393.
Presented by
Dr. Rafael Moiteiro da Cruz, Lisbon, Portugal, and Dr. Cord Langner, Graz, Austria.